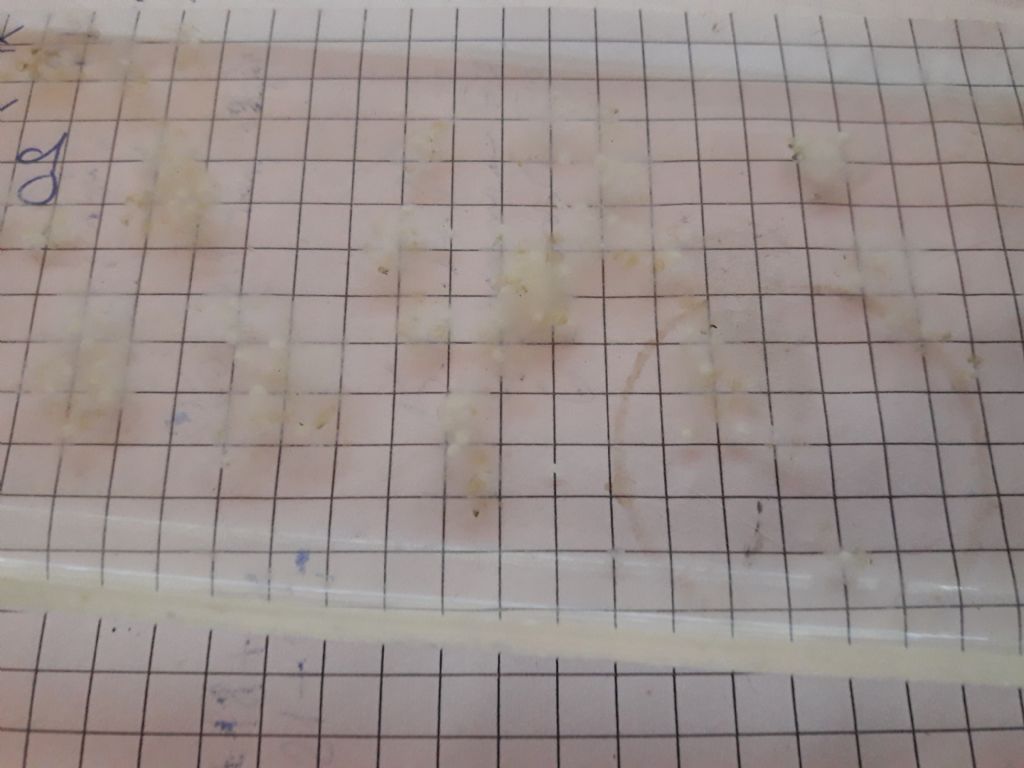

Hyphessobrycon flammeus Tetra Üretim Güncesi

05/02/2019 03:13:48

09/02/2019 00:05:37

17/02/2019 22:43:36

22/02/2019 17:07:47

25/02/2019 17:54:50

22/02/2019 17:11:59

25/02/2019 17:58:00

03/03/2019 12:06:31

09/03/2019 18:16:38

04/03/2019 18:47:11

04/03/2019 18:50:11

07/03/2019 17:49:31

13/03/2019 19:15:16

21/03/2019 22:00:01

18/03/2019 23:14:00

26/03/2019 18:25:19

25/04/2019 03:27:55

29/04/2019 18:01:51

13/03/2019 21:44:41

13/03/2019 21:44:41

29/04/2019 18:01:51

25/04/2019 03:27:55

26/03/2019 18:25:19

18/03/2019 23:14:00

21/03/2019 22:00:01

13/03/2019 19:15:16

07/03/2019 17:49:31

04/03/2019 18:50:11

04/03/2019 18:47:11

09/03/2019 18:16:38

03/03/2019 12:06:31

22/02/2019 17:11:59

25/02/2019 17:54:50

22/02/2019 17:07:47

17/02/2019 22:43:36

05/02/2019 03:13:48

05/02/2019 03:13:48

17/02/2019 22:43:36

22/02/2019 17:07:47

25/02/2019 17:54:50

22/02/2019 17:11:59

03/03/2019 12:06:31

09/03/2019 18:16:38

04/03/2019 18:47:11

04/03/2019 18:50:11

13/03/2019 19:15:16

21/03/2019 22:00:01

18/03/2019 23:14:00

26/03/2019 18:25:19

25/04/2019 03:27:55

29/04/2019 18:01:51
13/03/2019 21:44:41

13/03/2019 21:44:41

29/04/2019 18:01:51

25/04/2019 03:27:55

26/03/2019 18:25:19

18/03/2019 23:14:00

21/03/2019 22:00:01

13/03/2019 19:15:16

04/03/2019 18:47:11

09/03/2019 18:16:38

03/03/2019 12:06:31

22/02/2019 17:11:59

25/02/2019 17:54:50

22/02/2019 17:07:47

17/02/2019 22:43:36

05/02/2019 03:13:48

05/02/2019 03:13:48

17/02/2019 22:43:36

22/02/2019 17:07:47

25/02/2019 17:54:50

03/03/2019 12:06:31

09/03/2019 18:16:38

04/03/2019 18:47:11

13/03/2019 19:15:16

21/03/2019 22:00:01

18/03/2019 23:14:00

26/03/2019 18:25:19

25/04/2019 03:27:55

29/04/2019 18:01:51

13/03/2019 21:44:41

13/03/2019 21:44:41

29/04/2019 18:01:51

25/04/2019 03:27:55

26/03/2019 18:25:19

18/03/2019 23:14:00

21/03/2019 22:00:01

13/03/2019 19:15:16

04/03/2019 18:47:11

09/03/2019 18:16:38

03/03/2019 12:06:31

25/02/2019 17:54:50

22/02/2019 17:07:47

17/02/2019 22:43:36

05/02/2019 03:13:48

05/02/2019 03:13:48

17/02/2019 22:43:36

22/02/2019 17:07:47

25/02/2019 17:54:50

09/03/2019 18:16:38

04/03/2019 18:47:11

21/03/2019 22:00:01

18/03/2019 23:14:00

26/03/2019 18:25:19

25/04/2019 03:27:55

29/04/2019 18:01:51

13/03/2019 21:44:41

29/04/2019 18:01:51

25/04/2019 03:27:55

26/03/2019 18:25:19

18/03/2019 23:14:00

21/03/2019 22:00:01

04/03/2019 18:47:11

09/03/2019 18:16:38

25/02/2019 17:54:50

22/02/2019 17:07:47

17/02/2019 22:43:36

05/02/2019 03:13:48

05/02/2019 03:13:48

17/02/2019 22:43:36

25/02/2019 17:54:50

09/03/2019 18:16:38

04/03/2019 18:47:11

21/03/2019 22:00:01

18/03/2019 23:14:00

25/04/2019 03:27:55

25/04/2019 03:27:55

18/03/2019 23:14:00

21/03/2019 22:00:01

04/03/2019 18:47:11

09/03/2019 18:16:38

25/02/2019 17:54:50

17/02/2019 22:43:36

05/02/2019 03:13:48

05/02/2019 03:13:48

17/02/2019 22:43:36

25/02/2019 17:54:50

09/03/2019 18:16:38

21/03/2019 22:00:01

18/03/2019 23:14:00

25/04/2019 03:27:55

25/04/2019 03:27:55

21/03/2019 22:00:01

09/03/2019 18:16:38

25/02/2019 17:54:50

05/02/2019 03:13:48

05/02/2019 03:13:48

25/02/2019 17:54:50

09/03/2019 18:16:38

21/03/2019 22:00:01

25/04/2019 03:27:55

25/04/2019 03:27:55

21/03/2019 22:00:01

09/03/2019 18:16:38

05/02/2019 03:13:48

05/02/2019 03:13:48

09/03/2019 18:16:38

21/03/2019 22:00:01

25/04/2019 03:27:55

25/04/2019 03:27:55

21/03/2019 22:00:01

09/03/2019 18:16:38

05/02/2019 03:13:48

21/03/2019 22:00:01

25/04/2019 03:27:55

25/04/2019 03:27:55

21/03/2019 22:00:01

21/03/2019 22:00:01

25/04/2019 03:27:55

25/04/2019 03:27:55

25/04/2019 03:27:55

25/04/2019 03:27:55

25/04/2019 03:27:55

25/04/2019 03:27:55
Açıklama:
Bugünkü durum bu..[EDIT]kerem_altinoluk,2019-02-05 10:03:42[/EDIT]
Günışığı tetra 14 günlük .
300 lt. Yavrulukta....
Resimler için kusura bakmayin telefondan tam olarak açıklamalarını giremiyorum hergun resimlemeye çalışıyorum ..
Soran arkadaşlar için 1 uyarim var. Zevkine canlanmasina sebep olduklarımız Allah in verdiği canlardir. Sorumluluk bizimdir. [EDIT]kerem_altinoluk,2019-02-17 22:49:08[/EDIT]
Bugünkü durum.
Çok hızlı buyuyenler 300lt de
Büyükler küçükleri yutuyor.bu hem nüfusu azaltiyor hem bazılarını damızlık kullanılacak hale getiriyor.
[:nazar:]
Şuan öyleler...
[IMG]https://foto.akvaryum.com/fotolar/21182/030320191204461.jpg[/IMG][IMG]https://foto.akvaryum.com/fotolar/21182/030320191204561.jpg[/IMG][IMG]https://foto.akvaryum.com/fotolar/21182/030320191205021.jpg[/IMG][IMG]https://foto.akvaryum.com/fotolar/21182/030320191205101.jpg[/IMG][IMG]https://foto.akvaryum.com/fotolar/21182/030320191205191.jpg[/IMG][IMG]https://foto.akvaryum.com/fotolar/21182/030320191205301.jpg[/IMG]
Galaxy rasbora
Inci gurami
Alev tetra
Zebra danio
Gün ışığı tetra
Betta
Vatoz yavrularım
Kuhliyide çözdüm sayılır....
[IMG]https://foto.akvaryum.com/fotolar/21182/040320191843041.jpg[/IMG][IMG]https://foto.akvaryum.com/fotolar/21182/040320191843111.jpg[/IMG][IMG]https://foto.akvaryum.com/fotolar/21182/040320191843211.jpg[/IMG][IMG]https://foto.akvaryum.com/fotolar/21182/040320191843271.jpg[/IMG][IMG]https://foto.akvaryum.com/fotolar/21182/040320191843341.jpg[/IMG][IMG]https://foto.akvaryum.com/fotolar/21182/040320191843431.jpg[/IMG][IMG]https://foto.akvaryum.com/fotolar/21182/040320191843521.jpg[/IMG][IMG]https://foto.akvaryum.com/fotolar/21182/040320191843591.jpg[/IMG][IMG]https://foto.akvaryum.com/fotolar/21182/040320191844051.jpg[/IMG][IMG]https://foto.akvaryum.com/fotolar/21182/040320191844151.jpg[/IMG]
Yumurtadan 54 gun önce çıkan bugun bana yumurta veren gardnerilerimi unutmayalım. [IMG]https://foto.akvaryum.com/fotolar/21182/040320191849571.jpg[/IMG]
Püf Noktaları ve adım adım anlatım zaten her tür için internette mevcut.
Detay sadece sevgi ve emek. .
Bir sohbette ben ondan yavru aldım bundan yavru aldım dediğimde atma ordan diyenler var. Sadece tarihe not düşüyorum.
Amano karides için de resimlemeyi düşündüm ama sanırım insanlara anlatmak zor olacak.
[EDIT]Cyber_Scout,2019-03-04 21:21:11[/EDIT]
Boylanma hızı süper....
[IMG]https://foto.akvaryum.com/fotolar/21182/070320191748321.jpg[/IMG][IMG]https://foto.akvaryum.com/fotolar/21182/070320191748421.jpg[/IMG]
14.02.2019 da yumurtadan çıkan inci guramilerim 3 gündür yeni yerindeler.
Epiplaty killifishleriminde pozlarını paylaşmak istedim...
Neler yaptınız nasıl ürettiniz bunu günce olarak anlatmanız, sonucu paylaşmanızdan daha faydalı olacaktır diye düşünüyorum..[EDIT]Arifhb,2019-03-13 19:45:41[/EDIT]
Sonucu paylasmayacaksam üretiyoruz lafta kalır. Ispat isteyenler var.
Önemli
1.madde Anaçlar dezenfekte olmuş ve iyi besili olucak.yumurtalar olgun sperm yüklü olacak. Cinsiyetleri ayrı tutmak gerek.
2.madde Su. Uv yoksa kaynatılarak sterilize edilmiş su.
3.madde yumurtaları temiz tutmak dezenfekte etmek. Resimlerde olmalı nasıl yaptığım. Gorsel anlatmaktan kolay anlaşılır.
4.madde su hareketi. Yavrular tetralarin tümü için çok zayıf yumurtadan çıkar su hareketi dahada zayıflatır. Sonunda ölüm gelir.ne yapmalı serbest yuzunce 3 Gün beklemeli hepsi kendini toplasin infusoria yesin büyüsün. Sonra zayif akıntı filtrelemeye başla.
5.madde nüfus yoğunluğu. Bir dünya yumurtadan kimse kalmıyor bazen. Sebebi gözlem yapan görebilir. büyük yavrular küçük gelişmemiş yavruları yer. Resimleri inceleyenler ağız dolusu kardeşini yiyen balıkları görebilir. Boylama yapılarak düzeltilir.
Başka detaylar duruma ve şartların gereğince yapılmalıdır.
bu Hobiyi okuyarak ve deneyimleyerek gelistirirsiniz. Kimsede sihirli değnek yada bilgi yok hepsi birikimle oluyor.
Anlatabilmisimdir umarım. [EDIT]Cyber_Scout,2019-03-13 20:08:20[/EDIT]
En azından ben gibi dikjat edecek ve umursayacak bir çok arkadaş olduğundan adım gibi eminim. Tecrübe etmek başlı başına pratik bilgidir zaten, ben faydalanmak isterim.
Teşekkürler
[/QUOTE]
Merhaba, bu maddeyi anlayamadım, yumurtalar çatlayıp yavrular serbest yüzmeye başlayana kadar nasıl bir bakim yapilmali? Metilen mavisi kullanımı yeterli oluyor mu?
Temizlerin içindeki beyazlar tohumlanmamış . Sanirim tetralardan 1 erkek kısır.
Dezenfekte edilmemiş yada işlemi geç kalan yumurtalardaki mantar ve temiz yumurta ile dezenfeksiyon. Anlaşılır durumda sanirim[EDIT]Cyber_Scout,2019-03-13 21:46:38[/EDIT]
Gunsonu...
Sayamıyorum. 300 lt. + 40 +40 +75 lt fullenmek üzere.
Üretmek kolay zor olan insanlara satmak..
Paranı alabilmek.
Ismi lazım olmayan bir pet ithalatçısı soyle dedi :Tabi canım herkez üretiyor ben ithalattan 3 te 1 i fiyatına getiriyorum. 3 tl ye sattığımi 1 yada 75 kr. Tan verirsen alırım.
Arkadaş ne demek lazımsa onu diyorum.
Herkez milli ve yerli ....
Ithalati benim gibi hobici arkadaşlar bitirebilecekse çok pufuruk bir iş yapiyorlar demek.
Acıyorum insanlarımiz ne ara bu hale geldi...
[IMG]https://foto.akvaryum.com/fotolar/21182/210320192149061.jpg[/IMG][IMG]https://foto.akvaryum.com/fotolar/21182/210320192149121.jpg[/IMG][IMG]https://foto.akvaryum.com/fotolar/21182/210320192149191.jpg[/IMG][IMG]https://foto.akvaryum.com/fotolar/21182/210320192149261.jpg[/IMG][IMG]https://foto.akvaryum.com/fotolar/21182/210320192149321.jpg[/IMG][IMG]https://foto.akvaryum.com/fotolar/21182/210320192149391.jpg[/IMG][IMG]https://foto.akvaryum.com/fotolar/21182/210320192149451.jpg[/IMG][IMG]https://foto.akvaryum.com/fotolar/21182/210320192149521.jpg[/IMG][IMG]https://foto.akvaryum.com/fotolar/21182/210320192149591.jpg[/IMG][IMG]https://foto.akvaryum.com/fotolar/21182/210320192150051.jpg[/IMG][IMG]https://foto.akvaryum.com/fotolar/21182/210320192150111.jpg[/IMG][IMG]https://foto.akvaryum.com/fotolar/21182/210320192150161.jpg[/IMG][IMG]https://foto.akvaryum.com/fotolar/21182/210320192150221.jpg[/IMG][IMG]https://foto.akvaryum.com/fotolar/21182/210320192150271.jpg[/IMG][IMG]https://foto.akvaryum.com/fotolar/21182/210320192150341.jpg[/IMG][IMG]https://foto.akvaryum.com/fotolar/21182/210320192150411.jpg[/IMG][IMG]https://foto.akvaryum.com/fotolar/21182/210320192150471.jpg[/IMG][IMG]https://foto.akvaryum.com/fotolar/21182/210320192150541.jpg[/IMG][IMG]https://foto.akvaryum.com/fotolar/21182/210320192151011.jpg[/IMG]
Son parti son.. bir daha yumurtlamayacağım. Üretmeyeceğim. Kim için değerli..
Benim için. Ithallattan hastalık getirmeye devam edin....
Geçen 2 sene ben de melek üretimi yapmıştım. Birkaç petshopla görüşmüştüm o zaman. Dudaklarının ucuyla getir bakalım, belki 50krş 75 krş veririz adedine diyorlardı. Aynı boyda sağlıksız balıkları 10-15 TL ye satıyorlardı. Ben de kızdım bunlara ve buradan ilan verdim. Ve adedlerine ve boylarına göre 1TL ile 50TL arasında sattım ürettiklerimi.
Ha diyeceksin emeklerini karşıladı mı? Tabiki hayır. Ama az çok hobi masraflarımı çıkartmıştı.
Bence siz de verin ilan buradan. İllaki alıcısı çıkacaktır. Benden alanların çoğu; Petshoptan alıp da akvaryumuma hastalık taşımak istemiyorum diyen akvaryumuna değer veren arkadaşlardı.
Mesela ben 10 adet kadar inci guraminize talibim. İlanınızı bekliyorum [:)]
[EDIT]fahri-,2019-03-23 11:23:02[/EDIT]
8 yaşında babası. .
Yavrular verebilirim. Bilen kişi yavrudanda büyütür. Ilan veriyorum türleri ama insanımız biraz bilinçsiz. Hobinin suyunu çıkarıyorlar. .
Türleri ithal diye alıyor aldığı yere ben veriyorum zaten. Satıcıya Menşei saadetnamesi zorunlu olmalı. . Gelişmeli benim vatanım ve vatandaşım.
Tetralar ilanda
Kerevit ilanda
Killifish ilanda.
Imzada geçen türlerin satılabilir halde olanları ilana koyuyorum.
Satilamayacak boyda olanları ilana koyamam. Yavru fiyatta yazdığım ilanlar var ama küçükmus deniliyor. Yaşlı balık sevdamiz yüksek.[EDIT]Cyber_Scout,2019-03-23 22:40:23[/EDIT]
Yıllar yıllar önce, Akvaryum Kulubü'nde yumurtadan balık üretimi yapanlara "serbest yumurtacı" isimini önermiştim. Canlıdoğurancı, tuzlusucu, bitkici, Tropheus'cu falan gibi... Serbest yumurtacı. Siz hakiki bir serbest yumurtacısınız.
Tetra türlerini, barbus, danio türlerine oranla, daha az sevimli bulurum. Ağız yapıları itibarıyla bana biraz vahşi görünürler. Ancak çektiğiniz yavru fotoğrafları oldukça sevimli çıkmışlar. Onlar da ayrı bir güzellik...
Hayatta kalmak için çok vicdansizlar tüm turlerde gozlemledim.
Hobici var bu balik ne tür diye soran.
Hobici var cinsiyeti çözemeden üretip köşe dönmek isteyen. Benim gibi Yumurtacılar var. Ama Havyarci demek yerinde olmalı.
Teşekkür ederim. [EDIT]Cyber_Scout,2019-03-23 23:07:34[/EDIT]
[IMG]https://foto.akvaryum.com/fotolar/21182/260320191821241.jpg[/IMG][IMG]https://foto.akvaryum.com/fotolar/21182/260320191821351.jpg[/IMG][IMG]https://foto.akvaryum.com/fotolar/21182/260320191821521.jpg[/IMG][IMG]https://foto.akvaryum.com/fotolar/21182/260320191822051.jpg[/IMG][IMG]https://foto.akvaryum.com/fotolar/21182/260320191822151.jpg[/IMG][IMG]https://foto.akvaryum.com/fotolar/21182/260320191822251.jpg[/IMG][IMG]https://foto.akvaryum.com/fotolar/21182/260320191822341.jpg[/IMG][IMG]https://foto.akvaryum.com/fotolar/21182/260320191822471.jpg[/IMG]
Tum süreçleri paylaşmış olduğumu düşünüyorum. Umarım faydalanmışsinizdir...
Edindiğiniz bilge ve tecrübenizi de paylaştığınız için teşekkür ederim [:)]
Inci Gurami ve inci rasbora aynı karede iyi seyirler...
Günde 4 tatlı kaşığı yem ve artemia yetmiyor 1 akvaryuma...
Yakinda yarım kuzu yerler..
[IMG]https://foto.akvaryum.com/fotolar/21182/290420191758131.jpg[/IMG][IMG]https://foto.akvaryum.com/fotolar/21182/290420191758231.jpg[/IMG][IMG]https://foto.akvaryum.com/fotolar/21182/290420191758361.jpg[/IMG][IMG]https://foto.akvaryum.com/fotolar/21182/290420191758471.jpg[/IMG][IMG]https://foto.akvaryum.com/fotolar/21182/290420191758571.jpg[/IMG][IMG]https://foto.akvaryum.com/fotolar/21182/290420191759101.jpg[/IMG][IMG]https://foto.akvaryum.com/fotolar/21182/290420191759231.jpg[/IMG][IMG]https://foto.akvaryum.com/fotolar/21182/290420191759371.jpg[/IMG]
Canlılarım
- Rineloricaria sp. (Kırmızı Kertenkele Kedibalığı - L010A) L10 Red Lizard
- Betta macrostoma (Brunei Güzeli) Betta Macrostoma
- Trichogaster leerii (İnci Gurami) Inci Gurami - Trichogaster Leerii
- Betta krataios Betta Dimidiata - Firefly
- Nothobranchius guentheri Nothobranchius Guentheri Zanzibar
- Limia nigrofasciata (Kambur Limia) Limia Nigrofasciata - Humpback Limia
- Cambarellus patzcuarensis (Meksika Cüce Portakal Kereviti) Cambarellus Diminutus
- Dermogenys pusillus (Halfbeak) Halfbeak Platinum - Dermogenys Pusillus
- Betta rubra Betta Rubra
- Fundulopanchax gardneri gardneri (Gardneri Killifish - Yıllık Balığı) Fundulopanchax Gardneri
- Betta pi Betta Simorum
- Betta simplex Betta Simplex
- Parosphromenus deissneri (Meyankökü Gurami) Parosphromenus Deissneri
- Sphaerichtys vaillanti (Samuray Gurami) Sphaerichtys Vaillanti
- Betta persephone Betta Persephone
- Nothobranchius guentheri Nothobranchius Guentheri Zanzibar
- Carinotetraodon travancoricus (Pigme Puffer) Carinotetraodon Travancoricus - Pigme Puffer
- Macropodus opercularis (Cennet Balığı) Macropodus Opercularis (cennet Balığı)
- Oryzias latipes (Japanese Rice Fish, Japon Pirinç Balığı) Medaka Japon Pirinç Balığı (oryzias Latipes)
- Betta albimarginata Betta Albimarginata
- Tateurndina ocellicauda (Tavuskuşu Gobi) Tateurndina Ocellicauda - Tavuskuşu Gobi
- Dario dario (Kırmızı Badis) Dario Dario- Red Scarlet
- Rineloricaria sp. (Kırmızı Kertenkele Kedibalığı - L010A) Rineloricaria - Red Lizard L010a
- Danio margaritatus (Gök İncisi Danio - Galaxy Rasbora) Danio Margaritatus-galaxy Rasbora
- Oryzias latipes (Japanese Rice Fish, Japon Pirinç Balığı) Oryzias Latipes (medaka)
- Hyphessobrycon flammeus Tetra Üretim Güncesi
- Danio margaritatus (Gök İncisi Danio - Galaxy Rasbora) Galaxy Rasbora
